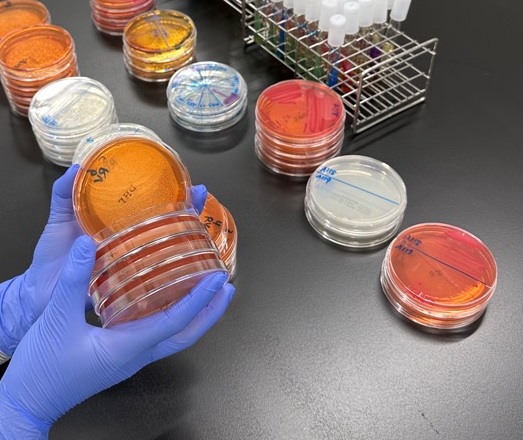

保健所検査課 【食品検査】
登録日:2026年4月6日
ホーム検査受付保菌検査飲用水検査浴槽水検査業務紹介(微生物)業務紹介(理化学)よくある質問
食品検査について
加工食品の検査(微生物検査・理化学検査)を受け付けています。
⒈ 微生物学的検査(検査項目・検査手数料)
- 検体をお持ちいただいた際に、検査項目に応じた検査手数料をお支払いいただきます。
| 主な検査項目 | 検査手数料 |
|---|---|
| 細菌数 | 3,050円 |
| 大腸菌 | 3,050円 |
| 大腸菌群 | 3,050円 |
| 腸管出血性大腸菌 | 7,410円 |
| 黄色ブドウ球菌 | 3,050円 |
| サルモネラ | 7,410円 |
| カンピロバクター | 9,040円 |
| ウエルシュ菌 | 9,040円 |

⒉ 理化学的検査(検査項目・検査手数料)
- 検体をお持ちいただいた際に、検査項目に応じた検査手数料をお支払いいただきます。
| 主な検査項目 | 検査手数料 |
|---|---|
| シアン化合物 | 4,410円 |
| ソルビン酸 | 16,780円 |
| デヒドロ酢酸 | 16,780円 |
| 安息香酸 | 16,780円 |


⒊ 検査のご依頼者
- どなた様でもご依頼可能です。ご希望に沿った検査項目をお選びください。
- 主に食品関係事業者様からご依頼をいただいております。
⒋ 申し込み方法
- 食品検査は完全予約制となっておりますので、お電話または保健所検査課(4階)の窓口にて担当者と検査項目の相談をしていただきます。
- 検査項目によって検査受付可能日が限られておりますので、あらかじめご了承下さい。
⒌ 結果の通知
- 郵送(投かん)となります。
※窓口でのお受け取りをご希望の場合は、検査申込時にお伝えください。
※保健所生活衛生課 食品衛生係に検査結果を検査課から直接提出することができます。ご希望の方は、受付時にお申し付けください。

このページに関するお問い合わせ先
保健福祉部 保健所検査課
電話番号: 0246-27-8598 ファクス: 0246-27-8601





